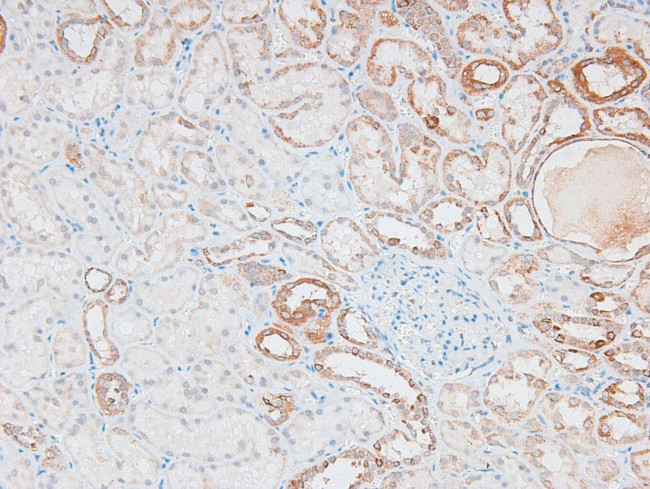
Phospho-IKK epsilon (Ser172) Antibody in Immunohistochemistry (Paraffin) (IHC (P))

Search
Invitrogen
Phospho-IKK epsilon (Ser172) Polyclonal Antibody
{{$productOrderCtrl.translations['antibody.pdp.commerceCard.promotion.promotions']}}
{{$productOrderCtrl.translations['antibody.pdp.commerceCard.promotion.viewpromo']}}
{{$productOrderCtrl.translations['antibody.pdp.commerceCard.promotion.promocode']}}: {{promo.promoCode}} {{promo.promoTitle}} {{promo.promoDescription}}. {{$productOrderCtrl.translations['antibody.pdp.commerceCard.promotion.learnmore']}}
图: 1 / 4
Phospho-IKK epsilon (Ser172) Antibody (PA5-105888) in IHC (P)




Please note: We are reviewing Western blot images included in the antibody testing data in our catalog, including those provided by third parties. Unless expressly labeled or annotated as “raw-unedited”, Western blot images included in the antibody testing data in our catalog may have been edited, optimized or otherwise adjusted for presentation.
产品信息
PA5-105888
种属反应
宿主/亚型
分类
类型
抗原
偶联物
形式
浓度
规格
纯化类型
保存液
内含物
保存条件
运输条件
RRID
产品详细信息
Antibody detects endogenous levels of IKK epsilon only when phosphorylated at Ser172.
靶标信息
IKBKE is an activator of nuclear factor-kappa-B. Over expression of IKBKE has been observed in breast cancer cells, and suppression of IKBKE induces cell death. NF-kappa-B is a ubiquitous transcription factor and an essential mediator of gene expression during activation of immune and inflammatory responses. NF-kappa-B mediates the expression of a great variety of genes in response to extracellular stimuli. NF-kappa-B is associated with Ikappa-B proteins in the cell cytoplasm, which inhibit NF-kappa-B activity. Ikappa-B is phosphorylated by Ikappa-B kinase (IKK) complex that contains IKK-a, IKK-b, and IKK-gamma. A novel molecule in the IKK complex was recently identified and designated IKK-iota/IKK-i. IKK epsilon is required for the activation of NF-kappa-B by PMA and T cell receptors but not by TNF-a and IL-1. IKK-iota/IKK-i message is expressed in a variety of tissues and is inducible by TNF-a, IL-1, and LPS.
仅用于科研。不用于诊断过程。未经明确授权不得转售。
篇参考文献 (0)
生物信息学
蛋白别名: I-kappa-B kinase epsilon; IKK-E; IKK-epsilon; IKK-i; Inducible I kappa-B kinase; inducible IKappaB kinase; inhibitor of kappa light polypeptide gene enhancer in B-cells, kinase epsilon; inhibitor of kappaB kinase epsilon; Inhibitor of nuclear factor kappa-B kinase subunit epsilon; RP11-534L20.1
基因别名: AW558201; IKBKE; IKK-i; IKKE; IKKepsilon; IKKI; KIAA0151
UniProt ID: (Mouse) Q9R0T8
Entrez Gene ID: (Rat) 363984, (Mouse) 56489